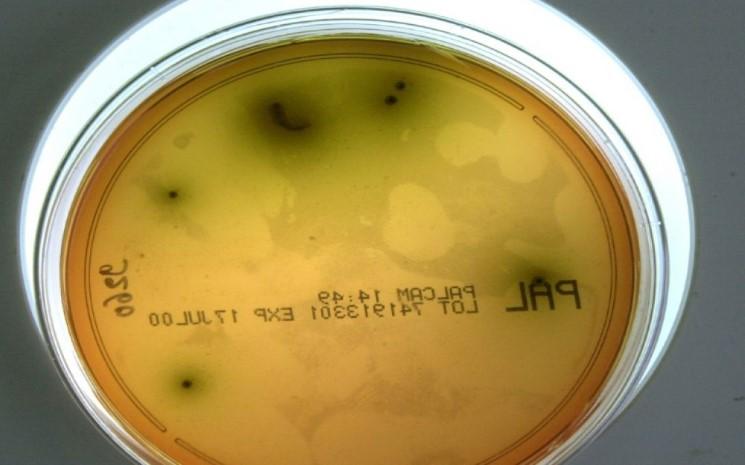
listeria, listériose, Afrique du Sud

La pire épidémie de listériose jamais enregistrée au monde est en cours en Afrique du sud, voilà la conclusion de l’Organisation Mondiale de la Santé. Depuis janvier 2017, 915 cas ont été confirmés. Au total, 172 personnes sont décédées de cette maladie infectieuse selon le gouvernement sud-africain, et environ 40 % des victimes étaient des nouveau-nés de moins d’un an.
« Etant donné l’ampleur de la mystérieuse épidémie, un délégué d’un centre de traitement de la maladie a évoqué le terme ‘’d’hystérie de la listériose’’ » a commenté The Times de Johannesburg. Particulièrement létale, la listeria peut se retrouver dans divers environnements (eaux, sols, animalier, humain, végétal), dans lesquels elle est capable de survivre des mois, voire des années. Chez l'homme, elle se contracte le plus souvent lors de la consommation d’aliments contaminés. La majorité des personnes infectées ont été répertoriées dans la région du Gauteng (nord-est), dont la capitale est Johannesburg.
Comment prévenir des risques ?
La bactérie est sournoise. Il n’existe aucune différence entre une nourriture contaminée et une nourriture saine. Même odeur, même goût, même apparence. Pour éviter tout risque, il faut redoubler de prudence sur les dates limites de consommation. Après ouverture, la nourriture doit être consommée dans les deux ou trois jours qui suivent.
Les réfrigérateurs doivent être constamment maintenus en dessous de 4°C, puisqu’au-dessus, la bactérie listeria est dans un milieu propice pour se développer. La cuisson (au moins 30 minutes) à des températures supérieures à 65 °C détruit la bactérie.
Il est fermement déconseillé de consommer de la charcuterie. Les viandes crues, pâtés et produits de la mer sont aussi à proscrire, de la même façon que des produits laitiers (lait cru, fromage à pâte molle et à croûte, …)
Les individus sensibles, comme les personnes âgées, les nouveau-nés, les femmes enceintes ou les patients au système immunitaire affaibli, sont les profils les plus exposés à la maladie.
Un manque d’organisation ?
Une prise en charge précoce, suivie par un traitement antibiotique, est relativement efficace afin d’éviter toute aggravation de la maladie. Malgré cela, le bilan continue de s’alourdir. Outre un possible manquement préventif et de prise en charge médical, il est aussi possible de se questionner sur l’insuffisance des contrôles alimentaires en Afrique du Sud.
L’Organisation Mondiale de la Santé a chargé des experts de suppléer le gouvernement sud-africain. Objectif : identifier les sources de l’épidémie. Le pays a besoin d’urgence d’une restructuration de son système alimentaire. De nombreux journaux nationaux rappellent que moins de 2.000 professionnels de la santé environnementale sont chargés de contrôler la provenance et la vente des denrées alimentaires. Selon l’OMS, il en faudrait plus du double. De son côté, les autorités sud-africaines appellent la population à respecter des règles basiques d'hygiène, tout en l'exhortant à « ne pas paniquer inutilement ».
Sur le même sujet